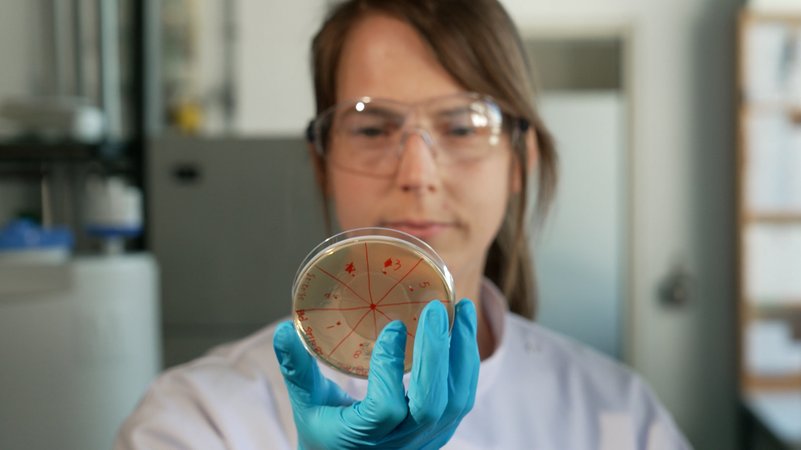
Ein Team der Technischen Universität München hat ein neues Verfahren zur schnelleren Bestimmung von Krankheitserregern mitentwickelt. | Bild: Bayerischer Rundfunk 2025 Ein Team der Technischen Universität München hat ein neues Verfahren zur schnelleren Bestimmung von Krankheitserregern mitentwickelt.

Bei Viruserkrankungen wie Corona dauert es nur wenige Minuten oder Stunden, bis wir wissen, ob wir positiv sind oder nicht. Bei Bakterien sieht die Sache anders aus: Um bei einer Erkrankung den möglichen Erreger zu bestimmen, müssen Bakterien erst vermehrt werden. Das kann mitunter sehr lange dauern. Ein Team der Technischen Universität München (TUM) unter der Leitung von Nicole Strittmatter hat jetzt zusammen mit Kollegen vom Imperial College London ein Verfahren entwickelt (externer Link), das die Bestimmungszeit drastisch verkürzt.
Massenspektrometrie weist Bakterien direkt nach
Statt Brutschränken für Bakterienkulturen stehen in der Abteilung für Analytische Chemie in Garching (externer Link) große Maschinen, sogenannte Massenspektrometer, die die Diagnose von bakteriellen Infektionen revolutionieren sollen. Sie können die Stoffwechselprodukte bestimmter Bakterienarten direkt aus den Gewebe-, Urin- oder Stuhlproben der Patienten bestimmen. Damit überspringen die Forscherinnen und Forscher einen Schritt in der bisherigen Diagnostik, die Ärzten wie auch Patienten eine Menge Geduld abverlangt.
Krankheitserreger in wenigen Minuten statt Wochen bestimmen
Beim herkömmlichen Nachweis werden zur Bestimmung der Krankheitserreger Kulturen angelegt, auf denen die Keime wachsen können. Bei manchen Erregern, wie etwa bei sogenannten Mykobakterien, den Erregern der Tuberkulose, braucht es allerdings selbst bei modernen Verfahren zwei oder drei Wochen, bis eine ausreichende Menge für eine sichere Bestimmung herangezüchtet ist. "Wenn man diesen Schritt überspringen könnte, dann könnte hier zum Beispiel viel gespart werden", erklärt Nicole Strittmatter.
Datenbank speichert "Fingerabdruck" der Erreger
Mithilfe der Massenspektrometrie ist den Wissenschaftlerinnen und Wissenschaftlern hier der Durchbruch gelungen. Die Ausscheidungsprodukte der Bakterien werden dabei in ihre Moleküle und Atome zerlegt, wodurch die Analysegeräte für jedes Bakterium eine charakteristische Zusammensetzung nachweisen können. Diese "Biomarker" werden in einer Datenbank gespeichert und können jederzeit für weitere Diagnosen abgerufen werden. Von den über 1.400 bekannten Bakterienarten, die Krankheiten hervorrufen, sind hier bereits 232 mit einem Marker gespeichert. Ziel des Teams ist es, alle Krankheitserreger zu erfassen.
Viele Vorteile, aber auch Grenzen der neuen Methode
Viele Wissenschaftler wie Lena Biehl vom Deutschen Zentrum für Infektionsforschung sehen in dem neuen Verfahren der Forschenden in Garching gleich mehrere Vorteile: Patienten könnten deutlich schneller und besser behandelt werden, auch wird damit im Falle eines positiven Tests das Umfeld des Patienten besser geschützt. Ganz auf Bakterienkulturen verzichten wird man in Zukunft wohl allerdings nicht. "Es fehlt für einige Fälle die Information, mit welchen Antibiotika wir diese Bakterien behandeln können." Für eine sogenannte "Resistenzbestimmung" werden auch in Zukunft Bakterienkulturen benötigt.
Krankheitserreger binnen Minuten statt Tagen oder gar Wochen identifizieren zu können, stellt dennoch einen bedeutenden Fortschritt bei der Diagnose von bakteriellen Erkrankungen dar.
Im Audio: So werden Krankheitserreger an der TUM binnen Minuten identifiziert
Erstautorin Wei Chen, Doktorandin an der TUM in Garching, befüllt das Massenspektrometer mit einer Probe.
Das ist die Europäische Perspektive bei BR24.
"Hier ist Bayern": Der BR24 Newsletter informiert Sie immer montags bis freitags zum Feierabend über das Wichtigste vom Tag auf einen Blick – kompakt und direkt in Ihrem privaten Postfach. Hier geht’s zur Anmeldung!